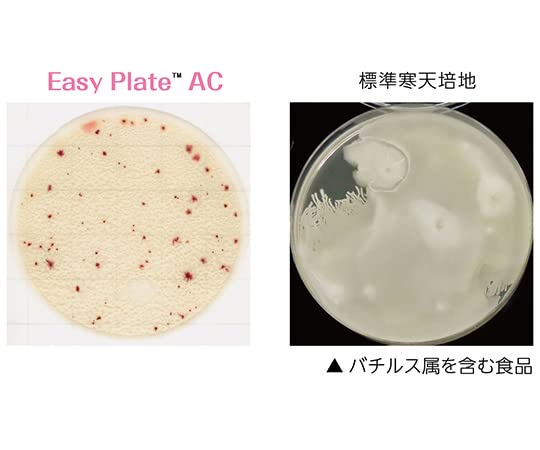

マイストア
変更
お店で受け取る
(送料無料)
配送する
納期目安:
2025.10.03 11:23頃のお届け予定です。
決済方法が、クレジット、代金引換の場合に限ります。その他の決済方法の場合はこちらをご確認ください。
※土・日・祝日の注文の場合や在庫状況によって、商品のお届けにお時間をいただく場合がございます。
とこです Amazon | キッコーマンバイオケミファ EasyPlate 一般生菌数測定の詳細情報
Amazon | キッコーマンバイオケミファ EasyPlate 一般生菌数測定。SKXおねじ付ソケット 中口径【ポリ管用】 | SKX中口径 | 製品。Amazon | キタコ(KITACO) 電源取り出しハーネス(カワサキ タイプ。フード付きのブラックステンカラーコート、The North Faceのロゴ刺繍入り。色は黒。よろしくお願い致します。キッコーマンバイオケミファ EasyPlate 一般生菌数測定用(25枚。1回着用の美品です。【未使用•タグ付】ジョセフアブード ステンカラーコート オフホワイト ストライプ。【極美品】ポールスミス ステンカラーコート。サイズはXL。Martin Margiela 白衣 ホワイト コート size38。良品◎バーバリー ステンカラーコート ノバチェック ライナー ロング ベージュM。
ベストセラーランキングです
近くの売り場の商品
カスタマーレビュー
オススメ度 4点
現在、2460件のレビューが投稿されています。

.jpg)
CS-(1).jpg)





















